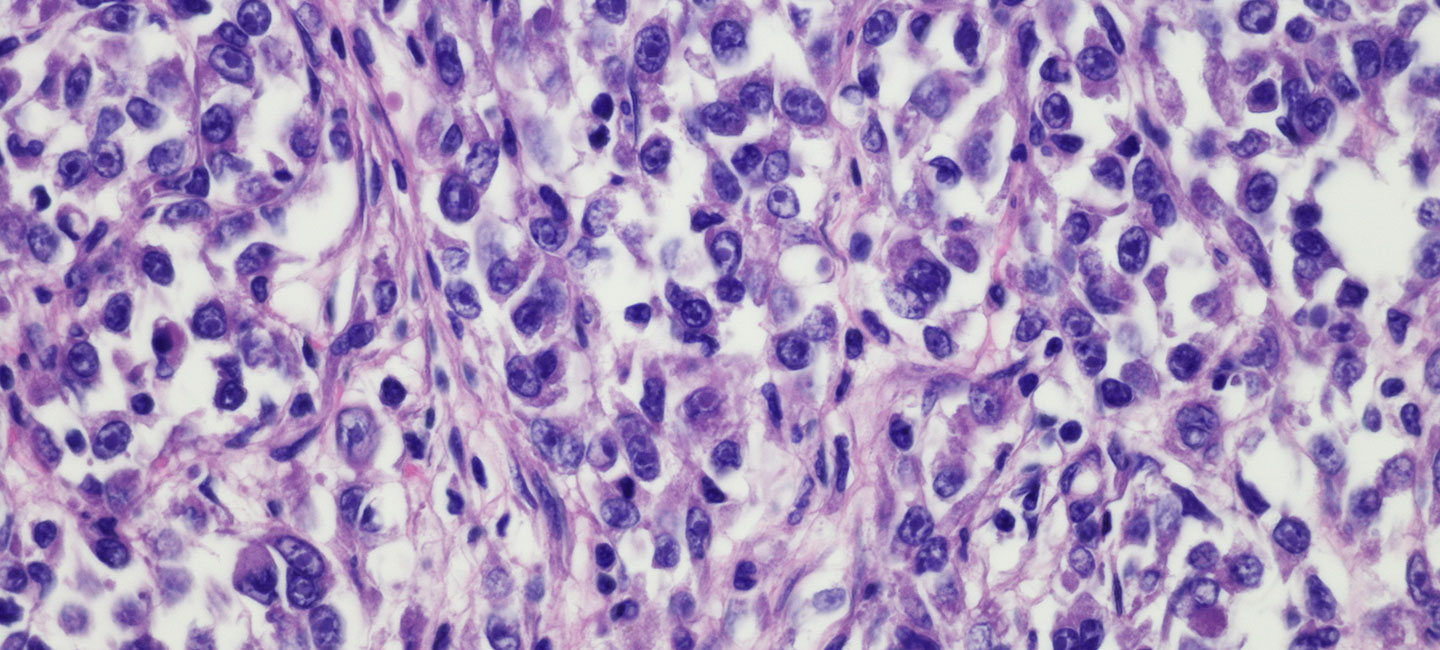

Expanded TIL Therapy Shows Promise for Sarcoma Patients
Considered to be among the great advances in oncology over recent years, tumor infiltrating lymphocyte (TIL) therapy and adoptive cell therapy (ACT) is a specific immunotherapy strategy that uses T cells to treat cancer. Patients receive an infusion that effectively “swaps” their peripheral, circulating T cells with those that are grown from a patient’s own tumor and thus tumor-responsive. While these treatments have been effective for treating metastatic melanoma and other hematologic tumors, the Sarcoma Oncology Program at Moffitt Cancer Center has developed a strategy to treat patients with soft tissue sarcoma in the same way.
Moffitt is currently treating adolescent and young adult (AYA) sarcoma patients on an ACT clinical trial and work in the lab is focused on optimizing the strategy further. AYA patients have the lowest clinical trial participation rate of all age groups and slower progress in survival improvement than younger patients, making this opportunity especially unique for patients. Dr. John Mullinax, an assistant member in Moffitt’s Sarcoma Department and the trial’s principal investigator, presented data from his lab at this year’s Society for Immunotherapy of Cancer (SITC) Annual Meeting in Washington, D.C. The results describe specific types of TIL (CD8+CD69+) that have shown increased tumor-specific response in soft tissue sarcoma and therefore represent a strategy to optimize the cell product that patients receive on future trials.
Until now, adoptive cell therapy using TIL has long been focused on melanoma because of its track record of success.

Dr. John Mullinax, Assistant Member, Sarcoma Oncology Program
“The big question of the current trial is, will these sarcoma patients tolerate the therapy well?” said Mullinax. “Melanoma patients are not commonly treated with the chemotherapy agents, so when they get TIL therapy, they are in a much different state in terms of performance status. Sarcoma patients, on the other hand, often receive many regimens of chemotherapy, as failure with systemic treatment is common. Since ACT can have toxicity, we are testing the ability of sarcoma patients to tolerate this treatment since the success seen in melanoma patients indicates great promise.”
Also at the SITC meeting, data was presented by Dr. Jonathan Metts, a pediatric oncologist at Johns Hopkins All Children’s Hospital, from a collaboration between Moffitt and All Children’s. In this report, Mullinax and Metts worked together to demonstrate that TIL can be expanded from pediatric solid tumor patients, providing a rationale for potential new trial opportunities in these very young patients.
“The other question is, do the TIL in pediatric patients grow like they do with adult patients?” said Mullinax. “Conventional wisdom has been that pediatric patients weren’t great candidates for ACT because a TIL product couldn’t be expanded from their tumors, but these results are promising. Through a collaboration with Dr. Metts at All Children’s and funded by the Ocala Royal Dames, we have shown that it is possible.”
Thanks to team science and collaboration between researchers and industry partners, future efforts will focus on expanding tumor-specific TIL for infusion in adults and also developing a trial concept to treat pediatric patients with this form of novel immunotherapy with the cooperation of pediatric oncologist colleagues.
“What sets Moffitt apart is our portfolio of clinical trials with multiple nonmelanoma solid tumor types such as sarcoma, head and neck squamous cell carcinoma, lung cancer and cervical cancer,” said Mullinax. “What we have here is the opportunity for sarcoma patients to have a cell therapy that’s homegrown and based on Moffitt science. I think the uniqueness of it, when you look around the country, is that the team approach to science at Moffitt has paid off in terms of a unique trial not offered at any other institution.”